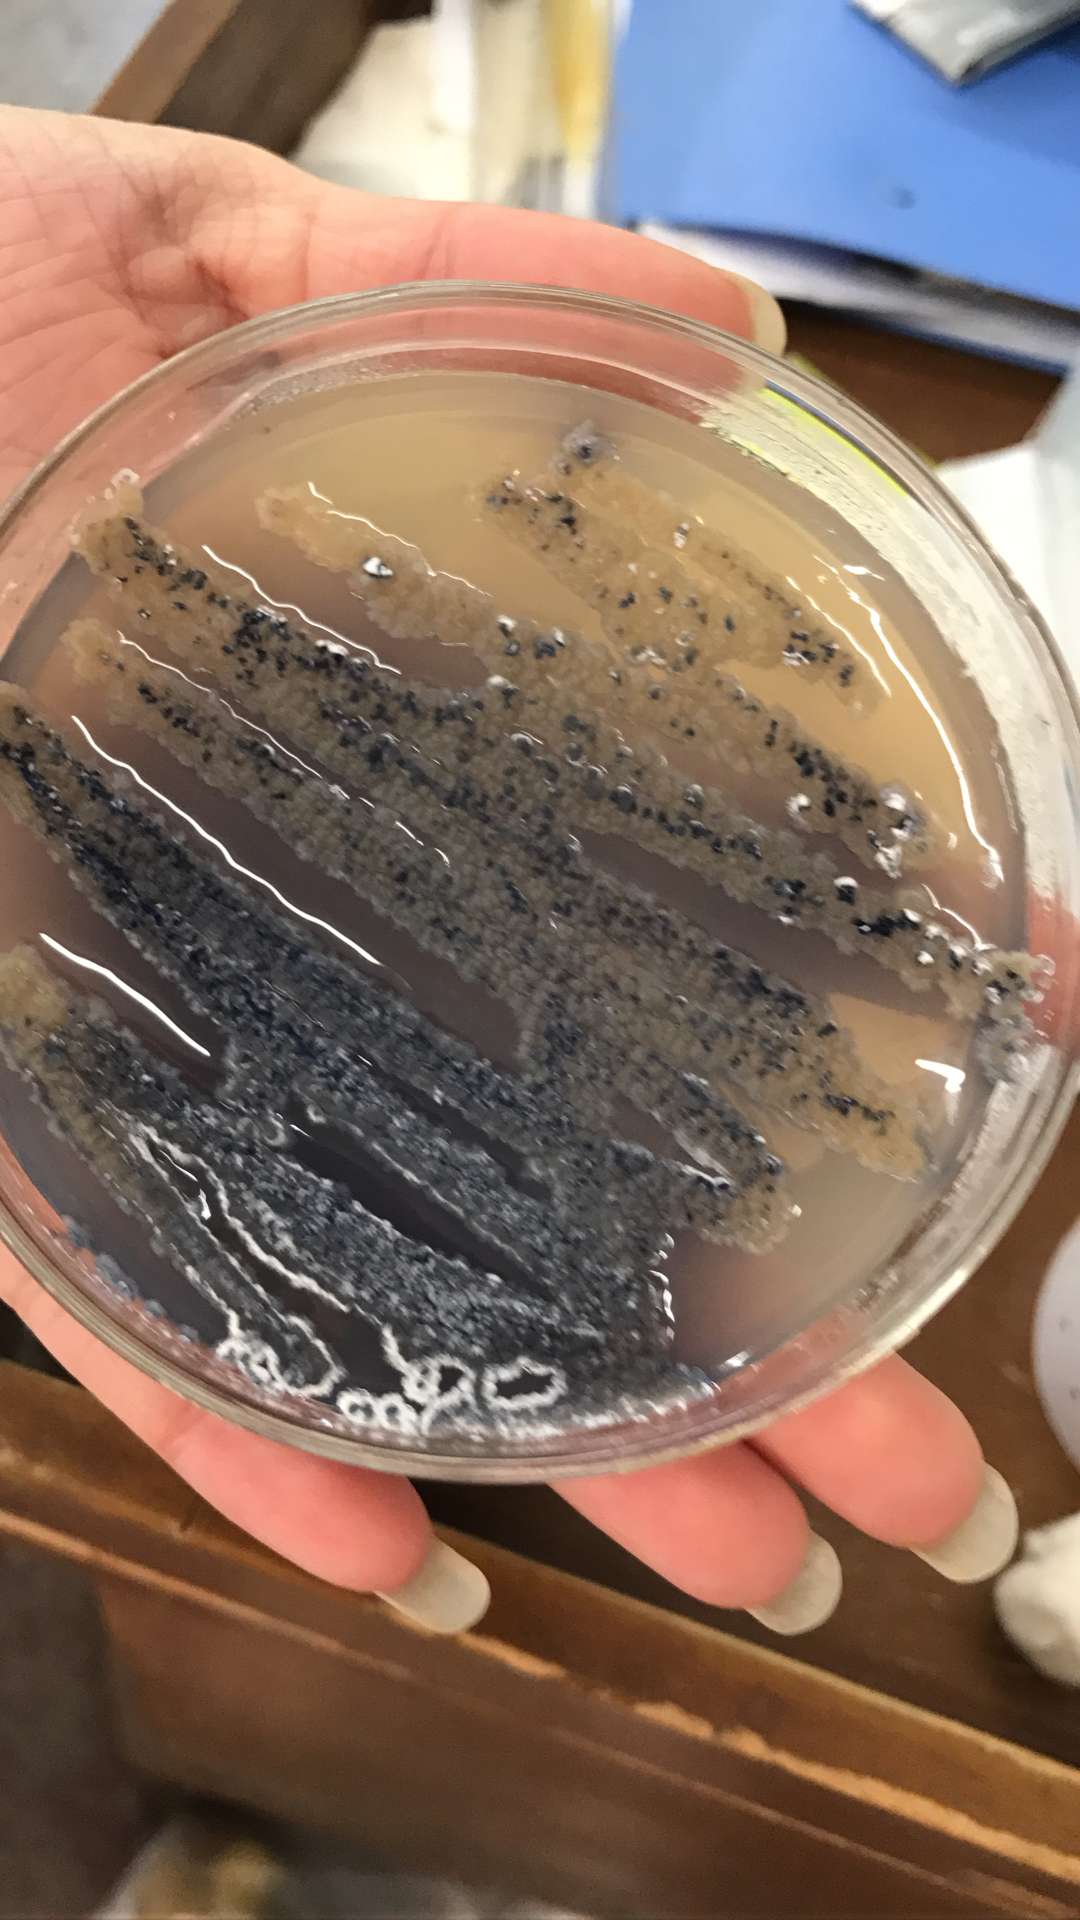
59695单bncc336594天蓝色链霉菌streptomycescoelicolorm

链孢霉

控制不住的链孢霉,立即喷洒索霉特
图片尺寸1152x2048
链孢霉正确预防措施和治疗方案
图片尺寸1080x1439
链格孢霉菌
图片尺寸633x442
中国林口-欢迎您
图片尺寸550x400
链孢霉 菌袋防控链孢霉,先用"菇博士"拌料预防,菌袋出现链 - 抖音
图片尺寸1080x1920
链孢霉正确预防措施和治疗方案
图片尺寸1080x1439
先泡3天大户麦秸水整地还田好方法防腐麦子好看好卖
图片尺寸1000x750
灵芝链孢霉防治办法
图片尺寸650x420
链孢霉 链锋8号 绿霉净食用菌大棚消毒接种室 竹荪病害 三王
图片尺寸1080x1440
感染链孢霉怎么办
图片尺寸640x853
一株具有广谱抗菌活性的链霉菌及其应用制造技术
图片尺寸920x1000
白色链霉菌
图片尺寸400x300
链霉菌
图片尺寸595x793
青霉和链孢霉容易区分.
图片尺寸666x831
放大200倍的链孢霉
图片尺寸550x440
产色链霉菌
图片尺寸576x430
食用菌链孢霉链孢霉杀菌剂索霉特
图片尺寸730x1125
链霉菌与奴卡菌鉴别要点
图片尺寸600x800
扩散到外源营养袋内的链孢霉
图片尺寸636x844
59695单bncc336594天蓝色链霉菌streptomycescoelicolorm
图片尺寸1080x1920